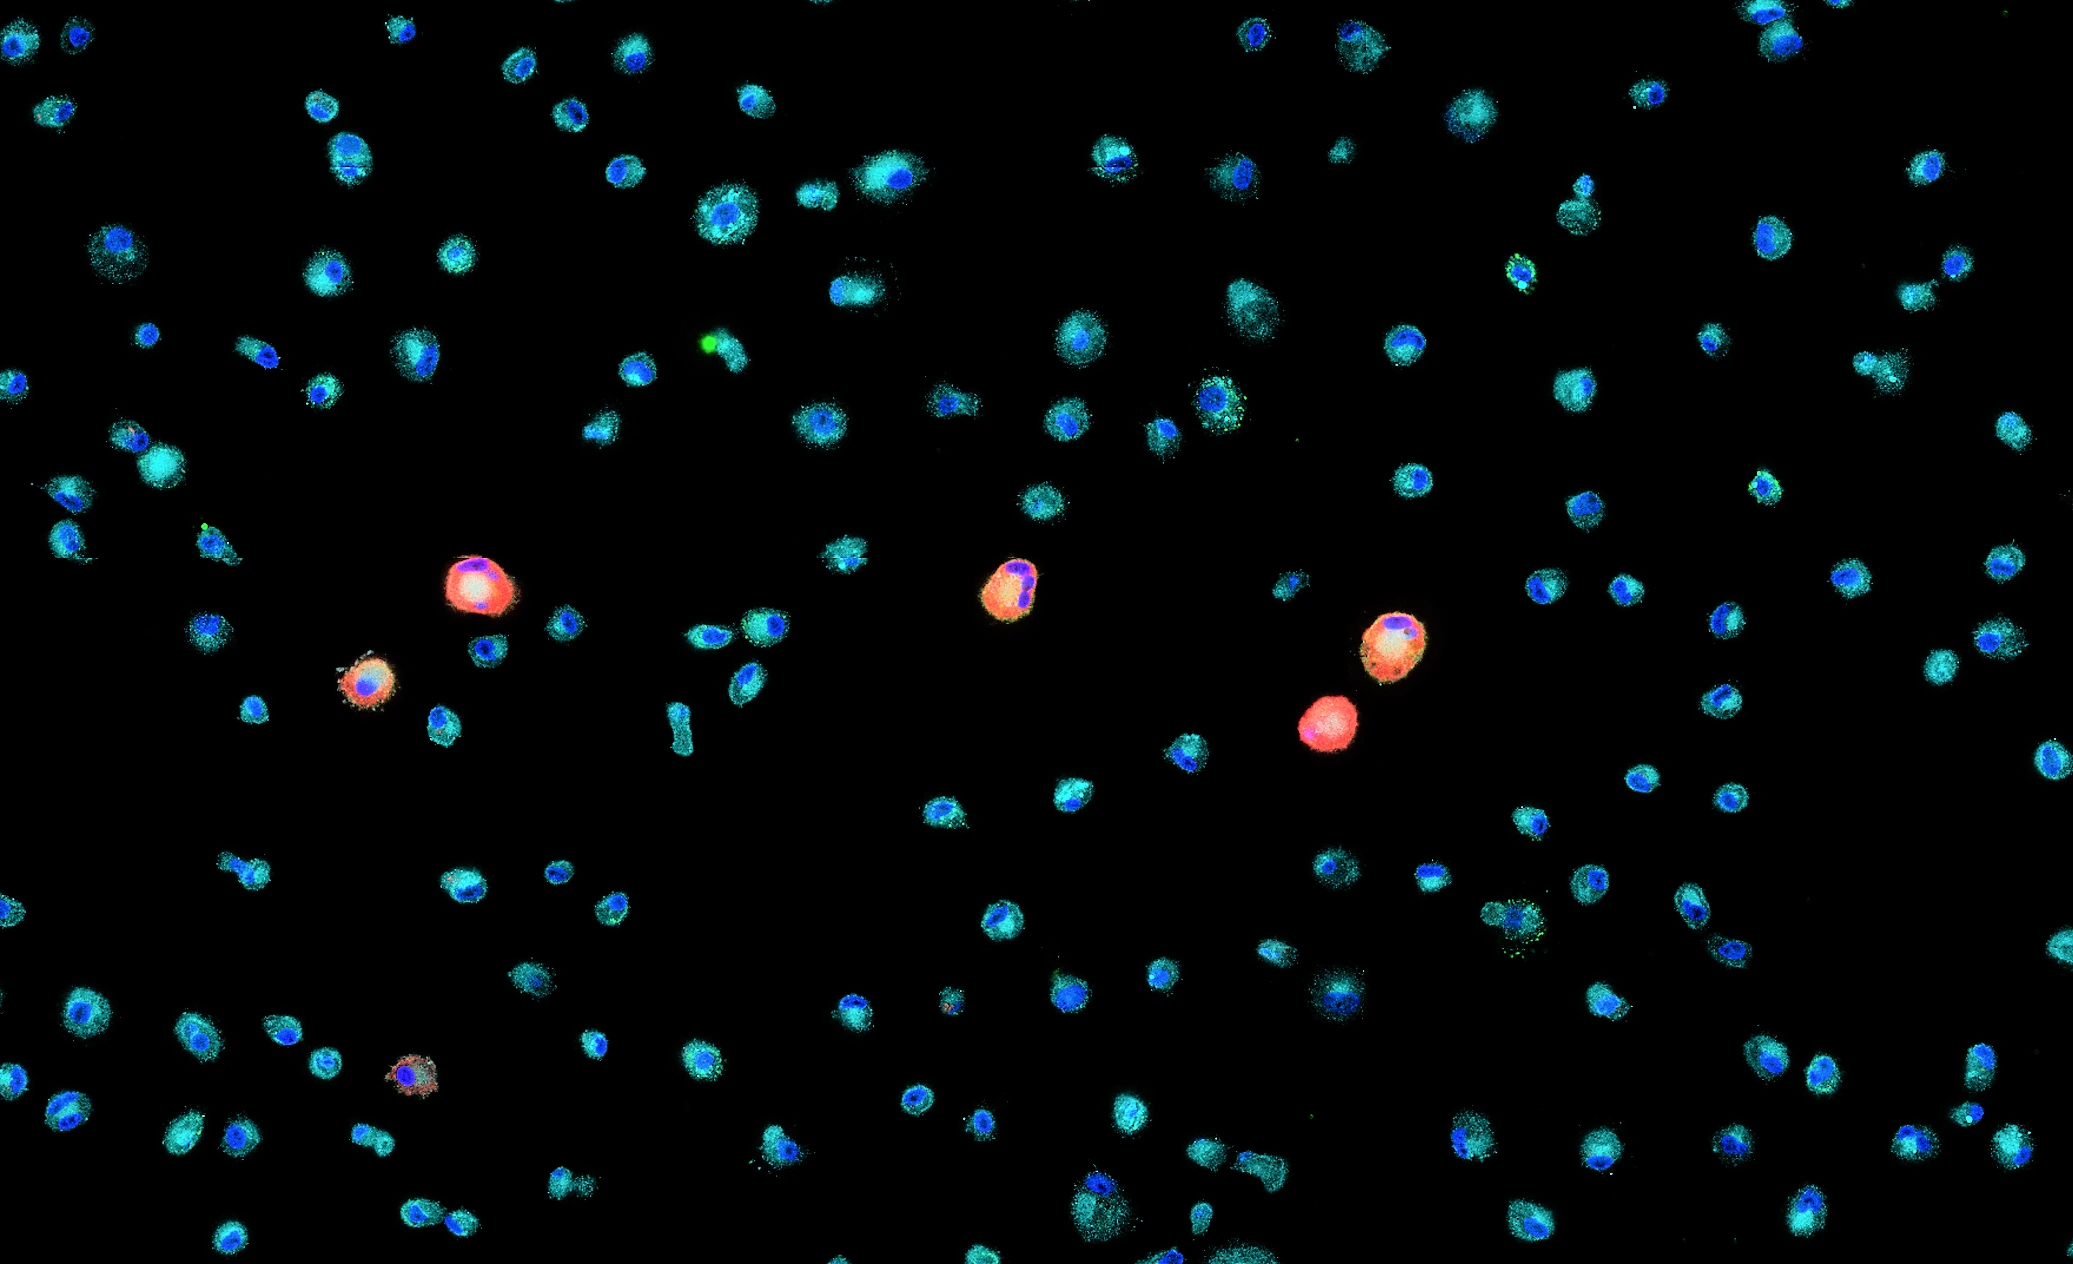

TissueFAXS
Brightfield & Fluorescence Base Imaging Systems
Upright and inverted slide scanners designed for versatile, high-quality imaging.
See what’s new in Version 8 ›
Software Suite 8 is here — DNN tissue detection, label capture with existing cameras, and a redesigned interface with smarter, more intuitive tools.

Flexible, High-Performance Slide Scanning
Engineered for precision across diverse applications.
TissueFAXS PLUS (upright) and TissueFAXS i PLUS (inverted) provide whole-slide imaging with support for brightfield and multichannel fluorescence. Optional modes include DIC, phase contrast, darkfield, and polarization. Both systems include autofocus, Z-stacking, and workflows for TMAs, well plates, and live-cell imaging. Upgrades to confocal, multispectral, or high-throughput imaging are available without replacing the system.
- Upright and inverted configuration
- Brightfield & fluorescence imaging
- Add-ons: DIC, phase contrast, darkfield, polarization
- Z-stacking and extended focus projection
- Dedicated workflow for TMAs, well plates, live-cell imaging
Why Choose TissueFAXS Plus?
TissueFAXS delivers high-quality images, fast results and a scalable design tailored to evolve with your lab’s needs.
Adaptable to Your Workflow.
Choose an upright or inverted setup to fit slides and/or well plates and Petri dishes.
Reliable Results, Simplified.
Custom scan profiles and integrated analysis streamline your workflow from acquisition to insight.
Built to Expand
Start with brightfield and fluorescence - expand later with multispectral, confocal, or slide loader.
Expert support you can count on
Our team supports you before, during, and after setup - with answers that go beyond the manual.
Compare Imaging Modes Side by Side
Explore how combining brightfield and fluorsecence reveals complementary structural and molecular detail.
Key features of Plus Systems
- Sample Type Compatibility
- Brightfield & Fluorescence Imaging
- TMA & Well-plate Workflow
- Live-Cell Imgaing
- Powerful Imaging Software
- Modular and Scalable Design
- Walkaway Automation
- Component Flexibility
- Integrated Image Analysis
- Unmatched Expert Support

Sample Type Compatibility
TissueFAXS systems support a broad range of sample carriers, including standard and oversized glass slides. In inverted configurations, additional compatibility includes well plates (6–96 wells), chamber slides, and Petri dishes. Custom stage inserts are available for non-standard formats. TissueFAXS can be utilized to image large tissue sections, TMAs, cell cultures, organoids, and cytospins.
Brightfield & Fluorescence Imaging
TissueFAXS Base supports both brightfield and fluorescence imaging with up to 7 markers for whole-slide acquisition. The open configuration allows researchers to validate and review samples directly through the microscope’s eyepiece, providing more flexibility than enclosed or boxed systems.


Dedicated TMA & Well Plate Workflow
TissueFAXS Plus configurations include a dedicated workflow for TMAs with up to 1,000 tissue cores per slide. In inverted systems, the same workflow also supports 6- to 96-well plates, enabling both tissue- and cell-based imaging. Features like automated core/well detection, per-well autofocus, and adjustable acquisition settings help maintain consistent image quality across varying sample types.
An intuitive interface allows researchers to define and edit TMA blocks, spots, and placeholders, making the system well-suited for labs performing both routine and multiplexed experiments.

Live-Cell & Time-Lapse Imaging
The inverted Plus configuration supports live-cell and time-lapse imaging for dynamic experiments, featuring scheduled, multi-region acquisition with precise control over timing intervals and scan cycles.
Compatible with chamber slides, multiwell plates, and Petri dishes, it is ideal for monitoring cell growth, migration, or drug response over time. Integrated environmental control modules for CO₂, temperature, and O₂ maintain stable physiological conditions throughout long-term imaging sessions.
Powerful Imaging Software
TissueFAXS features powerful imaging software designed to support both routine and advanced workflows. Users have full access to all scanning parameters allowing protocols to be precisely tailored and saved as reusable profiles for consistent results. Smart autofocus and Z-stacking with a Z-projection (extended focus) algorithm, improve clarity in thick or uneven samples, resulting in high-quality seamless images.
Integrated virtual slide viewing, annotation tools, and export to open data formats streamline review, sharing, and downstream analysis.

Modular and Scalable Design
TissueFAXS Multispectral is designed to perfectly suit your research needs - it comes equipped with an 8-slide stage ideal for a smaller capacity lab. Need to scan H&E or IHC-stained tissues too? TissueFAXS Multispectral supports both fluorescence and brightfield imaging modes. Plan a high-throughput research project? A 120-slide loader can be added for high-throughput studies or core facilities. Thanks to the system flexibility, your TissueFAXS system can grow with your lab.

Walkaway Automation and Integrated Label Reader
TissueFAXS supports walk-away automation with a fully motorized, computer-controlled system and automated workflows for a wide range of sample types and staining protocols. Key steps - like tissue detection, autofocus, and image acquisition - are handled automatically for both brightfield and fluorescence experiments.
Built-in barcode and QR code reading captures sample IDs during scanning, allowing for automatic slide tracking and accurate metadata assignment. With customizable scan profiles and batch processing, TissueFAXS makes it easy to run multi-slide projects unattended - while ensuring traceable, consistent, and reproducible results.


Component- Flexibility (Objectives, Cameras, Light Sources, Filters)
Users can choose from a variety of high-performance cameras optimized for both brightfield and fluorescence imaging; objectives ranging from 1x to 100x in air, water, or oil immersion—with support for up to seven simultaneously mounted; multiple light sources with configurable spectral outputs to match specific fluorophore combinations; and filter sets including single-, dual-, and quad-bandpass options.
This component-level flexibility allows configurations to be precisely tailored to specific experimental needs, from routine imaging to advanced multiplexed assays.
Seamless Integration with Image Analysis
TissueFAXS systems pair effortlessly with StrataQuest, enabling efficient, slide-to-data workflows for both upright and inverted configurations. After acquisition, researchers can run automated marker scoring, region detection, and intensity-based quantification—ideal for studies in biomarker expression, tumor margin analysis, and more.
In inverted setups, the system supports analysis of well plate-based live-cell imaging, including workflows for proliferation tracking, colony formation, and morphological profiling. It’s a versatile setup for labs handling both fixed tissue and live-cell experiments.

Specialized Expertise, Every Step of the Way
Our systems are backed by a multidisciplinary support team with expertise across hardware configuration, image analysis, and system maintenance.
Our application specialists help you define the optimal setup for your imaging needs, while our analysis experts assist in designing and refining StrataQuest pipelines tailored to your research. For more advanced needs, engineering and R&D teams are available to develop and integrate custom features or workflows, including new configurations beyond our standard portfolio.
Whether you're scaling your analysis or planning for future upgrades, expert guidance is built into every step.
System Configurations: Upright vs. Inverted

TissueFAXS Plus - Upright Microscopy System
- Upright configuration optimized for tissue sections, TMAs and cytospins
- Suitable for multichannel widefield fluorescence or brightfield microscopy
- Label-free imaging options: darkfield, phase contrast, DIC, and polarization
- Motorized filter wheel with 10 positions

TissueFAXS iPlus - Inverted Microscopy System
- Inverted configuration supports imaging of well plates (6–96), chamber slides, and Petri dishes
- Also supports imaging of tissue sections on slides
- Optional incubation modules for temperature, CO₂, and O₂ control
- Live cell imaging, cell culture and proliferation studies with time-lapse imaging
- Motorized filter wheel 6 positions
Interested in seeing TissueFAXS in action?
Explore TissueFAXS in Action
Our knowledge base provides valuable resources where Tissuegnostics' products were employed to push science forward - white papers, application notes and webinars.
Related Products

TissueFAXS Viewer
Free. Fast. Made for Collaboration.
TissueFAXS Viewer is a free, standalone desktop application for exploring high-resolution virtual slides generated by TissueFAXS systems. It allows researchers and collaborators to navigate brightfield, fluorescence, or multispectral scans, view annotations, and assess results without needing the full imaging setup. It's the ideal tool for sharing and reviewing data across teams.
StrataQuest Image Analysis
Turns imaging data into publication-ready results.
StrataQuest is a powerful analysis platform designed to work seamlessly with TissueFAXS. It transforms high-resolution images into meaningful data, supporting workflows from basic segmentation to AI-driven classification. Scalable and intuitive, it delivers insights into phenotypes, spatial patterns, and tissue architecture across a range of research applications.
- Customizable pipelines for basic & advanced image analysis
- AI-powered nuclei segmentation and tissue classification
- Spatial analysis tools (e.g. neighborhood, distance, clustering)
- Integrated data mining: t-SNE, UMAP, SONG, and more
- Prebuilt analysis apps for oncology, immunology, neurology, and more
- Open format support and direct integration with TissueFAXS systems

Let Us Know How We Can Support You
Couldn't find the answer to your question? Need assistance?
Whether you're imaging slides, well plates, or complex 3D samples, our team is here to help configure a TissueFAXS system that fits your exact workflow. From hardware recommendations to future upgrade planning, we’ll work with you to design a setup that’s ready for now and built for what’s next.
Technical Specifications
Feature | TissueFAXS Plus - Upright Slide Scanner | TissueFAXSi Plus - inverted Slide Scanner | ||
|---|---|---|---|---|
Sample Carrier | Carrier Types | glass slides | glass slides, chamber slides, well plates (6-96), petri dishes | |
Compatible Glass Slide Formats | Standard slide: 25 mm x 75 mm (1 in × 3 in) | |||
Cover Glass Thickness | 0.12 mm - 0.17 mm | |||
Design | Imaging Modes | widefield fluorescence, brightfield, darkfield*, phase contrast*, polarization*, DIC* | ||
Capacity | 8 standard slides | 8 standard slides, 1 well plate, 1 petri dish | ||
Objectives | motorized nosepiece for up to 7 (1x - 100x) air, oil or water | motorized nosepiece for up to 6 (1x - 100x) air oil or water | ||
Stage | motorized 8 slide stage (x,y,z) | |||
Workstation | HP Z6, High-performance Windows 11 PC for microscope control and analysis, including 2 x 27 high quality TFT monitors | |||
Incubation chamber* | n.a. | yes, for temperature, CO2 and O2 control | ||
Brightfield* | Light Source | VIS-LED: Lifetime > 10.000 hours | ||
Color Camera | Pixelink (CMOS): 2048 x 2048 px; 90.3 fps; up to 63% QE | |||
Scan Time | approx. 1.5 min (15 x 15 mm, 20x objective, pure scanning time, 1 focus point) | |||
Fluorescence | Light Source | Options: | ||
Monochrome Camera | Options: | |||
FL-Channels | motorized filter wheel, up to 10 positions | motorized filter wheel, up to 6 positions | ||
Scan Time | Standard FL scan: approx. 9 min (15 x 15 mm, 20x objective, 4 channels, 10ms exposure time, pure scanning time, 1 focus point) | |||
Dimensions | Measurements | 800 mm x 700 mm x 750 mm (31.5 in x 28 in x 30 in) | 800 mm x 700 mm x 700 mm (31.5 in x 28 in x 28 in) | |
Weight | 78 kg ± 5% (172.0 lbs ± 5%) | 75 kg ± 5% (165.4 lbs ± 5%) | ||
Operation | Temperature | +10 to +30°C (50 to 86°F) | ||
Humidity | below 40% is recommended; up to 80% without condensation | |||
Power Consumption | minimum 500 watts at peak, minimum of two power sockets 110/220 Volts (US/Europe) | |||
Software | Scanning | one click workflow, customizable workflows, access to all scanning parameters, automatic AI based tissue detection, automatic lable scanning, HDR and deconvolution**, smart autofocus, z-stacks and z-projections, automatic stiching for seamless whole slide image, dedicated TMA and well-plate workflow | ||
Image Export | aqproj (bioformats), OME tiff, tiff, png, jpg, bmp | |||
Image Viewer | Free TissueFAXS viewer - download here | |||
Analysis* | AI-based nuclei segmentation, real-time analysis preview, phenotyping and phenotype interactions, proximity measurement tool, AI training center**, dot detection, interactive diagrams, omics explorer**, unlimited multiplexing, library of prebuilt pipelines, data mining tools, customized statistics, versetail data export | |||
*optional
**to come in version 8.1
Trusted by Thousands of Researchers
Over 3,200 publications using TG solutions
Researchers worldwide rely on TG imaging and analysis platforms to generate high-quality, reproducible data across a wide range of fields—from oncology and immunology to neuroscience and regenerative medicine.
